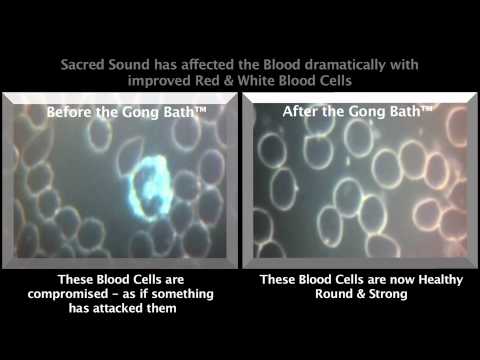
Youtube Video

1.8 hours
Highslopes Community Centre
Starting at GBP 25
Sun, 09 Nov, 2025 at 05:00 pm to 06:45 pm (GMT+00:00)
Highslopes Community Centre
Carlton Road, Portchester, United Kingdom
FOLLOW US ON SOCIAL MEDIA
IF TICKETS sold out CONTACT US directly please, WE MAY HAVE SOME CANCELLATION.
Awake Your Senses, Declutter Your Mind, Relax, Reset and Heal.
Since 2012, Beata and Jarek have dedicated their path to sharing the sacred sound of gongs. Through their awakening gong baths, they continue to hold a safe, loving space where others can awaken, reconnect with their true essence, and activate their natural self-healing abilities on their life journey.
You will be embraced with an organic vibrations of the sacred sound of The Universe created by top quality gongs: 40" Sri Yantra, 40" Uranus, 38" Sun, 38" Earth plus minimum of 6 other powerful gongs, 42" Shamanic Drum, Singing Bowls, Eagle Feathers and other divine instruments, Healing Voice and Unconditional Love.
DURING THE SESSION
You can meditate and sleep, or you may choose to stay awake and drift in and out of sleep throughout the session as the sound of the gongs and vibration gently washes over you.
The healing will finish with Shuniya - brief and silent time, just a couple of minutes that is called the “Shuniya” or “Sunyata”, literally meaning “emptiness” or “void”. This is the time for the sounds to settle, so the inner peace and the oneness will remain with you for the rest of the evening.
YOUR HOSTS
Beata and Jarek Dzwigol are Soul Mates connected by Love and our Passions. They provide Gong Baths since 2012 and All Night Gong Baths since June 2017.
is a Soul Wisperer.
Inter-Dimensional Therapist, Akashic Records Channeler, Gong and Reiki & Gong Master Teacher, and Spiritual Coach with over 20 years of experience.She offers one-on-one Akashic Records readings and Goddess Workshops, designed to help individuals—particularly women—connect with their soul’s purpose and reclaim their inner power. Guided by cosmic energies and Spiritual Guides,She is a wise woman who has been assigned to teach 12 Croissants AM course.
well known as Okide Soul is a Sound Alchemist.
Gong and Reiki & Gong Master Teacher, Spiritual Healer, Meditation Master and Tarot Reader with over 20 years of experience.
He teaches an alchemy of the sound and vibrations of the gongs and other instruments as a profound and professional tool for healing via Accredited Gong Player 100 hours course.
Jarek offers one -on -one Tarot Readings, Aura Reading, Spiritual Healing, Reiki, and Sound Therapy sessions with profound healing effects. He works with clients over the world. You can listen his meditation in Insite Timer.
His clients often describe him as "an honest, humble individual with profound goodness and genuine abilities in mediumship and clairvoyance."
WHAT TO BRING
We kindly ask you to leave all your personal belongings in the car. Bring only your
yoga mat or low, camping SINGLE airbed),
warm blankets or sleeping bag (something WARM to put under your back and to cover yourself),
pillow and anything you need to lie down comfortably during the session.
booster under the knees my be helpful to keep relaxed lower back and hips.
bottle of water.
crystals or jewellery with gemstones to cleanse and energise them.
BOOKING
As places are striclty limited and used to, we are fully booked, please book as soon as possible online to guarantee a place. To join the event the ticket has to be purchased online.
ARIVAL
Door will be open promptly at 4.40pm. Event will start promptly at 5pm
Late-comers will not be allowed in once the event is underway! so please take additional time to arrive.
Before entering the hall, please take a deep breath, release tensions, stress and calmly enter the room.
Once you enter to the room, please remain calm and peaceful. We create a relaxing, sacred space. You are welcome to chat to your friends after the session.
Please don't attend if you are feeling not well.
VENUE
Carlton Road, Fareham PO16 8JH
Free car park. Event suitable for disabled. Toilets available.
CONTRAINDIGATIONS
- Pregnancy (first trimester of pregnancy not recommended)
- Serious mental health problems
- Epilepsy/seizure
- Any surgery in the last 12 weeks*
If you are concerned about your health, contact your GP or us before purchasing the ticket.
Disclaimer: The amount and type of gongs and other instruments may change but always for better outcome. We always do channelling to receive guidance before the event. Client's results, and healing experience may vary from person to person.
For more information contact us on 07731 673759
PURCHASING THE TICKET
By purchasing the ticket, you and the person for whom you bought the ticket are confirming that you UNDESTAND AND AGREE to the Contraindications, Disclaimer Consent and Cancellation Policy by Life with Gongs and I Feel Good Therapy Clinic as below:
CANCELLATION POLICY
Tickets cannot be exchanged, refunded or used in the future events, unless the event is cancelled by Life with Gongs. If the event is cancelled by Life with Gongs we will organize a transfer of funds to you between 14-28 days from the date of the event (excl. eventbrite's fee).
DISCLAIMER CONSENT
NOTE: All photography rights reserved
To understand more about performed on professional, high quality Gong Bath benefits, please watch videos below.
Meet us closer... Small testimonials about our work and our gong baths.
We are so excited to share with you this very unique, saced space
With Love and Kindness
Beata, Julie and Jarek
For more information contact us on 07731 673759 or 07935651585
LIKE & FOLLOW US ON SOCIAL :
W: www.lifewithgongs.com
LIKE & FOLLOW JULIE'S SOCIAL
W: juliefastiggiyoga.co.uk
FOLLOW US ON SOCIAL MEDIA
Also check out other Health & Wellness events in Portsmouth, Workshops in Portsmouth.
Tickets for Awakening Gong Bath with 10 Gongs & 42" Drum on the Coast can be booked here.
| Ticket type | Ticket price |
|---|---|
| Supportive Ticket (low income) -arrival at 4.40pm | 25 GBP |
| Awakening Ticket - arrival 4.40pm | 31 GBP |
| Limited Early Bird | 28 GBP |